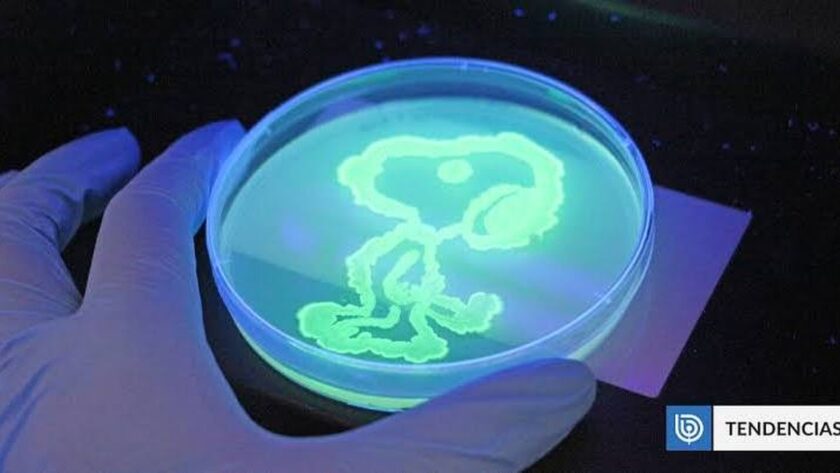

Inovativní experiment studentů inženýrství na Katolické univerzitě
Studenti inženýrství Katolické univerzity (UC) provedli inovativní experiment, jehož cílem bylo vytvářet kresby pomocí fluorescenční zelené proteiny (GFP) z medúzy Aequorea victoria. Před několika desetiletími tato fascinující proteina revolučně změnila svět molekulární biologie, protože umožňuje učinit neviditelné viditelným.
Fluoreskuje pod modrým nebo ultrafialovým světlem a v laboratořích se používá k sledování buněk a pozorování procesů v živých organismech v reálném čase, protože není toxická. Její objev byl v roce 2008 oceněn Nobelovou cenou za chemii. Nyní se studenti v Chile učí, jak ji využívat.
Vytváření umění s proteiny medúz
Tento experiment byl součástí programu Biologického inženýrství a biotechnologie na univerzitě. „Používáme fluorescenční zelenou proteinu jako viditelný způsob, jak učit bakterie a práci v biotechnologii,“ vysvětluje v prohlášení profesor Daniel Garrido, pedagog a ředitel oddělení chemického inženýrství a bioprocesů UC. „Ale také jsme otevřeli prostor pro to, aby studenti mohli rozvíjet umělecké dovednosti s těmito bakteriemi, jako by používali barvy,” dodává.
Cílem bylo, aby studenti aplikovali teoretické koncepty ze svého vzdělání v laboratoři. Také namalovali postavy Ballerina Capuchina a Stormtroopera ze Star Wars. Aby to bylo možné, pracovali s bakteriemi Escherichia coli, které byly transformovány pomocí plazmidu umožňujícího expresi GFP.
„Byla to velmi motivující zkušenost naučit se, co se děje v laboratoři a mít příležitost si hrát, tvořit a užívat si vědy,“ komentuje studentka Trinidad Peters. „Ačkoliv zde pracujeme s biomolekulou zelené barvy, tento stejný princip se využívá v reálných aplikacích, jako je degradace plastů, produkce inzulínu, protilátek nebo biologické diagnostiky,“ dodává její profesor.